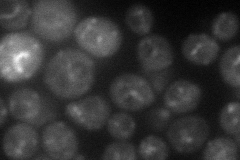
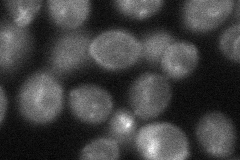

View description
Protein similar to mammalian oxysterol-binding protein; contains ankyrin repeats; localizes to the Golgi and the nucleus-vacuole junction
Localization:
Intensity:
Fold change:
Significance:
-
C’ GFP library in SD

below threshold17.57 -
N' NOP1pr-GFP in SD

punctate61.819 -
N' TEF2pr-mCherry in SD
punctate52.9386 -
N' NATIVEpr-GFP in SD

below threshold21.8637 -
N' TEF2pr-VC and Cyto-VN in SD
punctate44.6916 -
C’ GFP library in SD+DTT

cytosol16.890.96No -
C’ GFP library in SD+H2O2

cytosol16.940.96No -
C’ GFP library in Starvation Media

cytosol14.610.83No -
C’ GFP library on the background of Pup2-DaMP

below threshold -
C’ GFP library on the background of CCT mutant

below threshold18.46621.05088No
